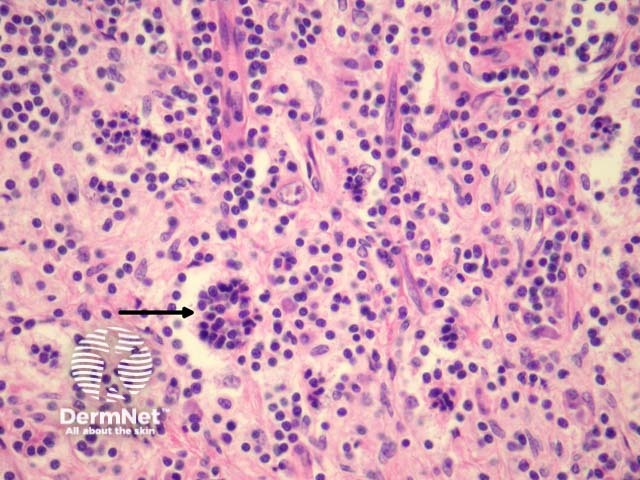
Figure 4
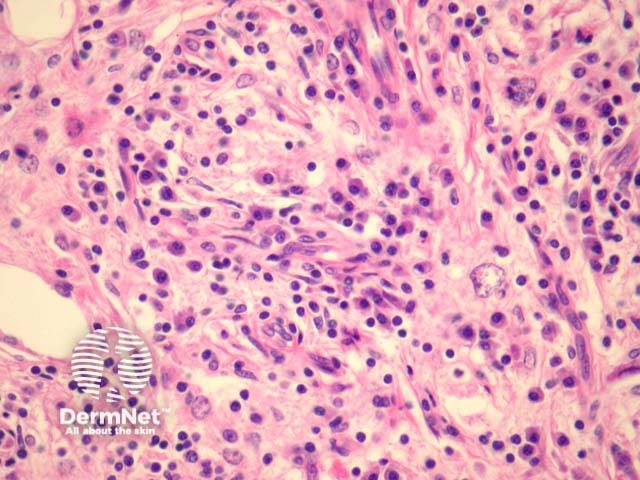
Figure 5

Main menu
Common skin conditions
NEWS
Join DermNet PRO
Read more
Quick links
Systemic diseases Diagnosis and testing
Author: Assoc Prof Patrick Emanuel, Dermatopathologist, Auckland, New Zealand, 2013.
Introduction Histology Special studies Differential diagnoses
Rosai-Dorfman Disease, also called sinus histiocytosis with massive lymphadenopathy, is a non-Langerhans histiocytic disease. The skin is the most common extranodal site. Cutaneous Rosai-Dorfman disease typically occurs in older females and presents in various forms, ranging from single papules to multiple nodules and plaques.
Rosai-Dorfman shows infiltration of the dermis or subcutaneous tissue with associated sclerosis (figures 1, 2). The infiltrate is composed predominantly of epithelioid histiocytes with a pale to eosinophilic cytoplasm. Some multinucleate forms may be seen. Admixed with these large histiocytes are lymphocytes, plasma cells, neutrophils and eosinophils.
The hallmark of Rosai-Dorfman disease is emperipolesis, in which lymphocytes and other inflammatory cells reside undisturbed within the cytoplasm of the histiocytes (figures 3, 4, arrows).
Plasma cells are frequently dense in cutaneous Rosai-Dorfman disease (figure 5). Because of this, some authors believe there is a relationship this disease and IgG4-related sclerosing diseases.

Figure 1

Figure 2

Figure 3
Figure 4
Figure 5
Histiocytes show positive staining for CD68 and S-100 in Rosai-Dorfman disease. CD1A is negative.
Other histiocytic diseases should not display emperipolesis.
Subcutaneous panniculitis-like T-cell lymphoma: the infiltrate is predominantly lymphocytic. There are histiocytes engulphing nuclear debris (bean bag cells) which should not be confused with emperipolesis. The lymphocytes demonstrate nuclear atypia and can be seen to characteristically rim the adipocytes.